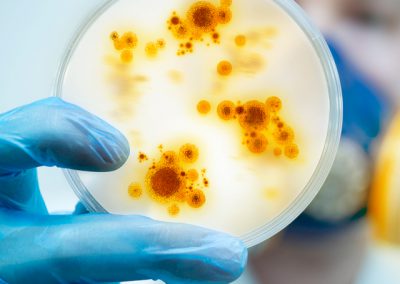

WORKPLACE SAFETY TRAINING COURSES
Today’s workplace can be extremely dangerous. In fact, hazards can lurk in seemingly safe environments like offices. Thankfully, a well-trained workforce is one of the best ways to protect your employees.
Our eLearning courses address some of the most common safety issues found in the workplace. From preventing back injuries and asbestos exposure to protecting against heat stress and hearing loss, we help raise awareness so your employees know what to do in virtually any scenario.